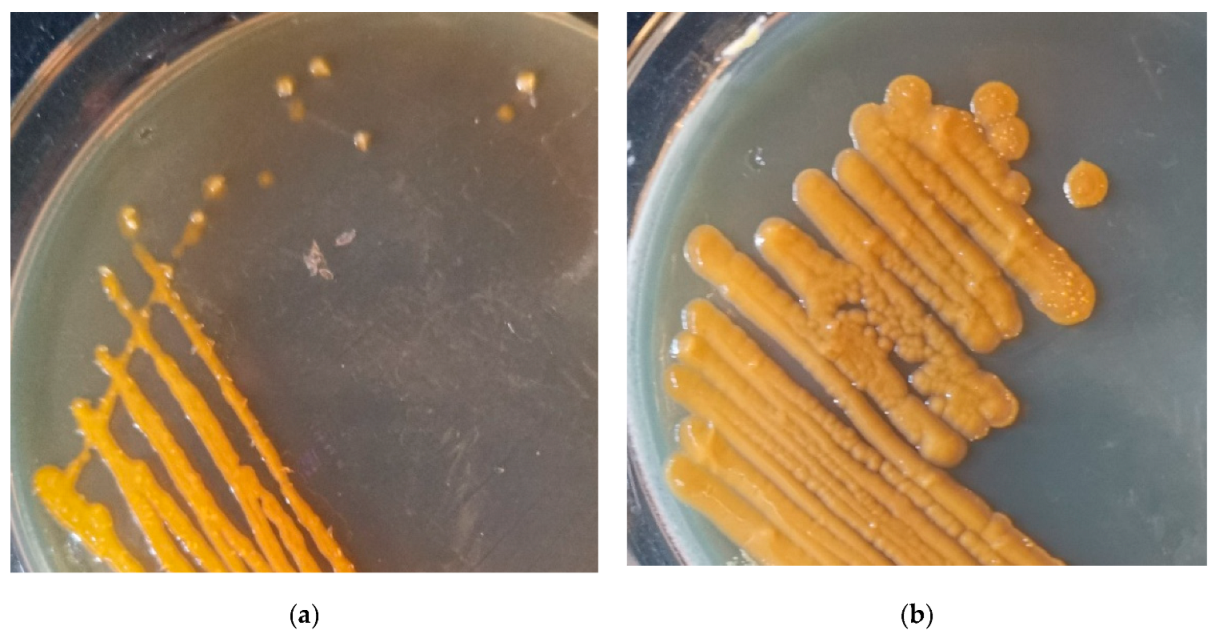
Microorganisms 11 00266 g005 Microorganisms 11 00266 g005

Comparative Genomic Analysis of Sphingomonas morindae sp. NBD5 and Sphingopyxis sp. USTB-05 for Producing Macular Pigment
Abstract
1. Introduction
2. Materials and Methods
2.1. Bacterial Strains
2.2. DNA Extraction and Sequencing
2.3. Genome Assembly and Quality Control
2.4. Genome Annotation
2.5. Detection of Lutein of Sphingomonas morindae sp. NBD5
2.6. Data and Drawing Tool
3. Results
3.1. General Features of the Genome
3.2. Gene Ontology Annotation
3.3. Cluster of Orthologous Groups Annotation
3.4. Gene Clusters and Pathway Associated with Lutein and Zeaxanthin Biosynthesis
3.5. Identification of Lutein of Sphingomonas morindae sp. NBD5 and Sphingopyxis sp. USTB-05
4. Discussion
5. Conclusions
Supplementary Materials
Author Contributions
Funding
Institutional Review Board Statement
Informed Consent Statement
Data Availability Statement
Conflicts of Interest
References
- Udayan, A.; Arumugam, M.; Pandey, A. Nutraceuticals From Algae and Cyanobacteria. Algal Green Chem. 2017, 65–89. [Google Scholar]
- Khachik, F.; Bernstein, P.S.; Garland, D.L. Identification of lutein and zeaxanthin oxidation products in human and monkey retinas. Investig. Ophthalmol. Vis. Sci. 1997, 38, 1802–1811. [Google Scholar]
- Wilson, L.M.; Tharmarajah, S.; Jia, Y.; Semba, R.D.; Schaumberg, D.A.; Robinson, K.A. The Effect of Lutein/Zeaxanthin Intake on Human Macular Pigment Optical Density: A Systematic Review and Meta-Analysis. Adv. Nutr. 2021, 12, 2244–2254. [Google Scholar] [CrossRef] [PubMed]
- Mrowicka, M.; Mrowicki, J.; Kucharska, E.; Majsterek, I. Lutein and Zeaxanthin and Their Roles in Age-Related Macular Degeneration-Neurodegenerative Disease. Nutrients 2022, 14, 827. [Google Scholar] [CrossRef] [PubMed]
- Scripsema, N.K.; Hu, D.N.; Rosen, R.B. Lutein, zeaxanthin, and meso-zeaxanthin in the clinical management of eye disease. J. Ophthalmol. 2015, 2015, 865179. [Google Scholar] [PubMed]
- Gazzolo, D.; Picone, S.; Gaiero, A.; Bellettato, M.; Montrone, G.; Riccobene, F.; Lista, G.; Pellegrini, G. Early Pediatric Benefit of Lutein for Maturing Eyes and Brain-An Overview. Nutrients 2021, 13, 3239. [Google Scholar] [CrossRef] [PubMed]
- Addo, E.K.; Gorusupudi, A.; Allman, S.; Bernstein, P.S. The Lutein and Zeaxanthin in Pregnancy (L-ZIP) study-carotenoid supplementation during pregnancy: Ocular and systemic effects-study protocol for a randomized controlled trial. Trials 2021, 22, 300. [Google Scholar] [CrossRef]
- Perrone, S.; Tei, M.; Longini, M.; Buonocore, G. The Multiple Facets of Lutein: A Call for Further Investigation in the Perinatal Period. Oxidative Med. Cell. Longev. 2016, 2016, 5381540. [Google Scholar] [CrossRef]
- Ren, Y.; Sun, H.; Deng, J.; Huang, J.; Chen, F. Carotenoid Production from Microalgae: Biosynthesis, Salinity Responses and Novel Biotechnologies. Mar. Drugs 2021, 19, 713. [Google Scholar] [CrossRef]
- Lin, J.H.; Lee, D.J.; Chang, J.S. Lutein production from biomass: Marigold flowers versus microalgae. Bioresour. Technol. 2014, 184, 421–428. [Google Scholar] [CrossRef]
- Sathasivam, R.; Bong, S.J.; Park, C.H.; Kim, J.H.; Kim, J.K.; Park, S.U. Identification, Characterization, and Expression Analysis of Carotenoid Biosynthesis Genes and Carotenoid Accumulation in Watercress (Nasturtium officinale R. Br.). ACS Omega 2022, 7, 430–442. [Google Scholar] [CrossRef] [PubMed]
- Liu, Y.; Yao, S.; Lee, Y.J.; Cao, Y.; Zhai, L.; Zhang, X.; Su, J.; Ge, Y.; Kim, S.G.; Cheng, C. Sphingomonas morindae sp. nov., isolated from Noni (Morinda citrifolia L.) branch. Int. J. Syst. Evol. Microbiol. 2015, 65, 2817–2823. [Google Scholar] [CrossRef] [PubMed]
- Zhang, Y.; Li, M.; Zhao, Z.; Liu, C.; Liu, Y.; Yan, H. A novel production of lutein by Sphingomonas morindae sp. NBD5. Fourrages 2020, 244, 99–109. [Google Scholar]
- Liu, C.; Xu, Q.; Zhao, Z.; Zhang, H.; Liu, X.; Yin, C.; Liu, Y.; Yan, H. Genomic Analysis of Sphingopyxis sp. USTB-05 for Biodegrading Cyanobacterial Hepatotoxins. Toxins 2022, 14, 333. [Google Scholar] [CrossRef]
- Wang, J.; Wu, P.; Chen, J.; Yan, H. Biodegradation of microcystin-RR by a new isolated Sphingopyxis sp. USTB-05. Chin. J. Chem. Eng. 2010, 18, 108–112. [Google Scholar] [CrossRef]
- Tamura, K.; Stecher, G.; Peterson, D.; Filipski, A.; Kumar, S. MEGA6: Molecular Evolutionary Genetics Analysis version 6.0. Mol. Biol. Evol. 2013, 30, 2725–2729. [Google Scholar] [CrossRef]
- Versluis, D.; McPherson, K.; Passel, M.W.J.; Smidt, H.; Sipkema, D. Recovery of previously uncultured bacterial genera from three mediterranean sponges. Mar. Biotechnol. 2017, 19, 454–468. [Google Scholar] [CrossRef]
- Haas, B.J.; Salzberg, S.L.; Zhu, W.; Pertea, M.; Allen, J.E.; Orvis, J.; White, O.; Robin, C.R.; Wortman, J.R. Automated eukaryotic gene structure annotation using EVidenceModeler and the Program to Assemble Spliced Alignments. Genome Biol. 2008, 9, R7. [Google Scholar] [CrossRef]
- Bland, C.; Ramsey, T.L.; Sabree, F.; Lowe, M.; Brown, K.; Kyrpides, N.C.; Hugenholtz, P. CRISPR Recognition Tool (CRT): A tool for automatic detection of clustered regularly interspaced palindromic repeats. BMC Bioinform. 2007, 8, 1–8. [Google Scholar] [CrossRef]
- Delcher, A.L.; Salzberg, S.L.; Phillippy, A.M. Using mummer to identify similar regions in large sequence sets. Curr. Protoc. Bioinform. 2003, 1, 10.3.1–10.3.18. [Google Scholar] [CrossRef]
- Qi, X.H.; Zhang, X.F.; Fan, X.L.; Zhang, F.; Wang, Y.F.; Xue, Q.; Zou, M.Q. Study on the ionization mechanism of lutein and lutein detected by Q-TOF under different ion sources. In Paper Presented at the Third China Third Party Testing Laboratory Development Forum; China Institute of Quarantine and Inspection Sciences: Beijing, China, 2011. (In Chinese) [Google Scholar]
- Rodrigues, D.B.; Mercadante, A.Z.; Mariutti, L.R.B. Marigold carotenoids: Much more than lutein esters. Food Res. Int. 2019, 119, 653–664. [Google Scholar] [CrossRef] [PubMed]
- Nguyet, N.; Ha, V.; Binh, N.T.; Dang, N.M.; Bay, N.T. Quantification of lutein from Marigold flower (Tagetes erecta L.) petals by liquid chromatography-tandem mass spectrometry method. Vietnam. J. Chem. 2019, 57, 2. [Google Scholar] [CrossRef]
- Strom, N.B.; Bushley, K.E. Two genomes are better than one: History, genetics, and biotechnological applications of fungal heterokaryons. Fungal Biol. Biotechnol. 2016, 3, 4. [Google Scholar] [CrossRef]
- Zuo, G.H.; Hao, B.L. CVTree3 Web Server for Whole-genome-based and Alignment-free Prokaryotic Phylogeny and Taxonomy. Genom. Proteom. Bioinform. 2015, 13, 321–331. [Google Scholar] [CrossRef]
- Jedrzejas, M.J.; Chander, M.; Setlow, P.; Krishnasamy, G. Mechanism of Catalysis of the Cofactor-independent Phosphoglycerate Mutase from Bacillus stearothermophilus: Crystal structure of the complex with 2-phosphoglycerate*. J. Biol. Chem. 2000, 275, 23146–23153. [Google Scholar] [CrossRef] [PubMed]
- Zhao, L.; Chang, W.C.; Xiao, Y.; Liu, H.W.; Liu, P. Methylerythritol phosphate pathway of isoprenoid biosynthesis. Annu. Rev. Biochem. 2013, 82, 497–530. [Google Scholar] [CrossRef] [PubMed]
- Sprenger, G.A.; Schörken, U.; Wiegert, T.; Grolle, S.; de Graaf, A.A.; Taylor, S.V.; Begley, T.P.; Bringer-Meyer, S.; Sahm, H. Identification of a thiamin-dependent synthase in Escherichia coli required for the formation of the 1-deoxy-d-xylulose 5-phosphate precursor to isoprenoids, thiamin, and pyridoxol. Proc. Natl. Acad. Sci. USA 1997, 94, 12857–12862. [Google Scholar] [CrossRef]
- Kuzuyama, T.; Takagi, M.; Takahashi, S.; Seto, H. Cloning and characterization of 1-deoxy-D-xylulose 5-phosphate synthase from Streptomyces sp. Strain CL190, which uses both the mevalonate and nonmevalonate pathways for isopentenyl diphosphate biosynthesis. J. Bacteriol. 2000, 182, 891–897. [Google Scholar] [CrossRef]
- Munos, J.W.; Pu, X.T.; Mansoorabadi, S.O.; Kim, H.J.; Liu, H.W. A secondary kinetic isotope effect study of the 1-deoxy-D-xylulose-5-phosphate reductoisomerase-catalyzed reaction: Evidence for a retroaldol-aldol rearrangement. J. Am. Chem. Soc. 2009, 131, 2048–2049. [Google Scholar] [CrossRef]
- Takahashi, S.J.; Kuzuyama, T.; Watanabe, H.; Seto, H. A 1-deoxy-D-xylulose 5-phosphate reductoisomerase catalyzing the formation of 2-C-methyl-D-erythritol 4-phosphate in an alternative nonmevalonate pathway for terpenoid biosynthesis. Proc. Natl. Acad. Sci. USA 1998, 95, 9879–9884. [Google Scholar] [CrossRef]
- Kuzuyama, T.; Takagi, M.; Kaneda, K.; Dairi, T.; Seto, H. Formation of 4-(cytidine 5′-diphospho)-2-C-methyl-D-erythritol from 2-C-methyl-D-erythritol 4-phosphate by 2-C-methyl-D-erythritol 4-phosphate cytidylyltransferase, a new enzyme in the nonmevalonate pathway. Tetrahedron Lett. 2000, 41, 703–706. [Google Scholar] [CrossRef]
- Rohdich, F.; Wungsintaweekul, J.; Fellermeier, M.; Sagner, S.; Herz, S.; Kis, K.; Eisenreich, W.; Bacher, A.; Zenk, M.H. Cytidine 5′-triphosphate-dependent biosynthesis of isoprenoids: YgbP protein of Escherichia coli catalyzes the formation of 4-diphosphocytidyl-2-C-methylerythritol. Proc. Natl. Acad. Sci. USA 1999, 96, 11758–11763. [Google Scholar] [CrossRef] [PubMed]
- Kuzuyama, T.; Takagi, M.; Kaneda, K.; Watanabe, H.; Dairi, T.; Seto, H. Studies on the nonmevalonate pathway: Conversion of 4-(cytidine 5′-diphospho)-2-C-methyl-D-erythritol to its 2-phospho derivative by 4-(cytidine 5′-diphospho)-2-C-methyl-D-erythritol kinase. Tetrahedron Lett. 2000, 41, 2925–2928. [Google Scholar] [CrossRef]
- Lüttgen, H.; Rohdich, F.; Herz, S.; Wungsintaweekul, J.; Hecht, S.; Schuhr, C.A.; Fellermeier, M.; Sagner, S.; Zenk, M.H.; Bacher, A.; et al. Biosynthesis of terpenoids: YchB protein of Escherichia coli phosphorylates the 2-hydroxy group of 4-diphosphocytidyl-2C-methyl-D-erythritol. Proc. Natl. Acad. Sci. USA 2000, 97, 1062–1067. [Google Scholar] [CrossRef]
- Takagi, M.; Kuzuyama, T.; Kaneda, K.; Watanabe, H.; Dairi, T.; Seto, H. Studies on the nonmevalonate pathway: Formation of 2-C-methyl-D-erythritol 2,4-cyclodiphosphate from 2-phospho-4-(cytidine 5′-diphospho)-2-C-methyl-D-erythritol. Tetrahedron Lett. 2000, 41, 3395–3398. [Google Scholar] [CrossRef]
- Herz, S.; Wungsintaweekul, J.; Schuhr, C.A.; Hecht, S.; Lüttgen, H.; Sagner, S.; Fellermeier, M.; Eisenreich, W.; Zenk, M.H.; Bacher, A.; et al. Biosynthesis of terpenoids: YgbB protein converts 4-diphosphocytidyl-2C-methyl-D-erythritol 2-phosphate to 2C-methyl-D-erythritol 2,4-cyclodiphosphate. Proc. Natl. Acad. Sci. USA 2000, 97, 2486–2490. [Google Scholar] [CrossRef]
- Okada, K.; Hase, T. Cyanobacterial non-mevalonate pathway: (E)-4-hydroxy-3-methylbut-2-enyl diphosphate synthase interacts with ferredoxin in Thermosynechococcus elongatus BP-1. J. Biol. Chem. 2005, 280, 20672–20679. [Google Scholar] [CrossRef]
- Seemann, M.; Bui, B.T.S.; Wolff, M.; Tritsch, D.; Campos, N.; Boronat, A.; Marquet, A.; Rohmer, M. Isoprenoid biosynthesis through the methylerythritol phosphate pathway: The (E)-4-hydroxy-3-methylbut-2-enyl diphosphate synthase (GcpE) is a [4Fe-4S] protein. Angew. Chem. 2002, 41, 4337–4339. [Google Scholar] [CrossRef]
- Seemann, M.; Wegner, P.; Schünemann, V.; Bui, B.T.S.; Wolff, M.; Marquet, A.; Trautwein, A.X.; Rohmer, M. Isoprenoid biosynthesis in chloroplasts via the methylerythritol phosphate pathway: The (E)-4-hydroxy-3-methylbut-2-enyl diphosphate synthase (GcpE) from Arabidopsis thaliana is a [4Fe-4S] protein. J. Biol. Inorg. Chem. 2005, 10, 131–137. [Google Scholar] [CrossRef]
- Rohdich, F.; Hecht, S.; Gärtner, K.; Adam, P.; Krieger, C.; Amslinger, S.; Arigoni, D.; Bacher, A.; Eisenreich, W. Studies on the nonmevalonate terpene biosynthetic pathway: Metabolic role of IspH (LytB) protein. Proc. Natl. Acad. Sci. USA 2002, 99, 1158–1163. [Google Scholar] [CrossRef]
- Wolff, M.; Seemann, M.; Bui, B.T.S.; Frapart, Y.; Tritsch, D.; Estrabot, A.G.; Rodríguez-Concepción, M.; Boronat, A.; Marquet, A.; Rohmer, M. Isoprenoid biosynthesis via the methylerythritol phosphate pathway: The (E)-4-hydroxy-3-methylbut-2-enyl diphosphate reductase (LytB/IspH) from Escherichia coli is a [4Fe-4S] protein. FEBS Lett. 2003, 541, 115–120. [Google Scholar] [CrossRef] [PubMed]
- Gräwert, T.; Kaiser, J.; Zepeck, F.; Laupitz, R.; Hecht, S.; Amslinger, S.; Schramek, N.; Schleicher, E.; Weber, S.; Haslbeck, M.; et al. IspH protein of Escherichia coli: Studies on iron-sulfur cluster implementation and catalysis. J. Am. Chem. Soc. 2004, 126, 12847–12855. [Google Scholar] [CrossRef] [PubMed]
- Sagami, H.; Ogura, K.; Seto, S.C.; Kurokawa, T. A new prenyltransferase from Micrococcus lysodeikticus. Biochem. Biophys. Res. Commun. 1978, 85, 572–578. [Google Scholar] [CrossRef] [PubMed]
- Takahashi, I.; Ogura, K. Farnesyl pyrophosphate synthetase from Bacillus subtilis. J. Biochem. 1981, 89, 1581–1587. [Google Scholar] [CrossRef] [PubMed]
- Ohnuma, S.I.; Suzuki, M.; Nishino, T. Archaebacterial ether-linked lipid biosynthetic gene. Expression cloning, sequencing, and characterization of geranylgeranyl-diphosphate synthase. J. Biol. Chem. 1994, 269, 14792–14797. [Google Scholar] [CrossRef]
- Tachibana, A.; Tanaka, T.; Taniguchi, M.; Susumu, O. Purification and Characterization of Geranylgeranyl Diphosphate Synthase from Methanobacterium thermoformicicum SF-4. Biosci. Biotechnol. Biochem. 1993, 57, 1129–1133. [Google Scholar] [CrossRef] [PubMed]
- Wiedemann, M.; Misawa, N.; Sandmann, G. Purification and Enzymatic Characterization of the Geranylgeranyl Pyrophosphate Synthase from Erwinia uredovora after Expression in Escherichia coli. Arch. Biochem. Biophys. 1993, 306, 152–157. [Google Scholar] [CrossRef] [PubMed]
- Shinka, T.; Ogura, K.; Seto, S. Comparative Specificity of Geranylgeranyl Pyrophosphate Synthetase of Micrococcus lysodeikticus and Pumpkin. J. Biochem. 1975, 78, 1177–1181. [Google Scholar] [CrossRef]
- Lang, H.P.; Cogdell, R.J.; Gardiner, A.T.; Hunter, C.N. Early steps in carotenoid biosynthesis: Sequences and transcriptional analysis of the crtI and crtB genes of Rhodobacter sphaeroides and overexpression and reactivation of crtI in Escherichia coli and R. sphaeroides. J. Bacteriol. 1994, 176, 3859–3869. [Google Scholar] [CrossRef]
- Hoshino, T.; Fujii, R.; Nakahara, T. Molecular cloning and sequence analysis of the crtB gene of Thermus thermophilus HB27, an extreme thermophile producing carotenoid pigments. Appl. Environ. Microbiol. 1993, 59, 3150–3153. [Google Scholar] [CrossRef]
- Vandermoten, S.; Haubruge, É.; Cusson, M. New insights into short-chain prenyltransferases: Structural features, evolutionary history and potential for selective inhibition. Cell. Mol. Life Sci. 2009, 66, 3685–3695. [Google Scholar] [CrossRef] [PubMed]
- Fraser, P.; Misawa, N.; Linden, H.; Yamano, S.; Kobayashi, K.; Sandmann, G. Expression in Escherichia coli, purification, and reactivation of the recombinant Erwinia uredovora phytoene desaturase. J. Biol. Chem. 1992, 267, 19891–19895. [Google Scholar] [CrossRef] [PubMed]
- Raisig, A.; Bartley, G.; Scolnik, P.; Sandmann, G. Purification in an Active State and Properties of the 3-Step Phytoene Desaturase from Rhodobacter capsulatus Overexpressed in Escherichia coli. J. Biochem. 1996, 119, 559–564. [Google Scholar] [CrossRef] [PubMed]
- Iniesta, A.A.; Cervantes, M.; Murillo, F.J. Cooperation of two carotene desaturases in the production of lycopene in Myxococcus xanthus. FEBS J. 2007, 274, 4306–4314. [Google Scholar] [CrossRef] [PubMed]
- Cunningham, F.X.; Sun, J.Z.; Chamovitz, D.; Hirschberg, J.; Gantt, E. Molecular structure and enzymatic function of lycopene cyclase from the cyanobacterium Synechococcus sp. strain PCC7942. Plant Cell 1994, 6, 1107–1121. [Google Scholar]
- Takaichi, S.; Sandmann, G.; Schnurr, G.; Satomi, Y.; Suzuki, A.; Misawa, N. The carotenoid 7,8-dihydro-ψ end group can be cyclized by the lycopene cyclases from the bacterium Erwinia uredovora and the higher plant Capsicum annuum. Eur. J. Biochem. 1996, 241, 291–296. [Google Scholar] [CrossRef]
- Maresca, J.; Graham, J.E.; Wu, M.; Eisen, J.A.; Bryant, D. Identification of a fourth family of lycopene cyclases in photosynthetic bacteria. Proc. Natl. Acad. Sci. USA 2007, 104, 11784–11789. [Google Scholar] [CrossRef]
- Stickforth, P.; Steiger, S.; Hess, W.R.; Sandmann, G. A novel type of lycopene ε-cyclase in the marine cyanobacterium Prochlorococcus marinus MED4. Arch. Microbiol. 2003, 179, 409–415. [Google Scholar] [CrossRef]
- Tan, C.P.; Zhao, F.Q.; Su, Z.L.; Liang, C.W.; Qin, S. Expression of β-carotene hydroxylase gene (crtR-B) from the green alga Haematococcus pluvialis in chloroplasts of Chlamydomonas reinhardtii. J. Appl. Phycol. 2007, 19, 347–355. [Google Scholar] [CrossRef]
- Choi, S.K.; Matsuda, S.; Hoshino, T.; Peng, X.; Misawa, N. Characterization of bacterial β-carotene 3,3´-hydroxylases, CrtZ, and P450 in astaxanthin biosynthetic pathway and adonirubin production by gene combination in Escherichia coli. Appl. Microbiol. Biotechnol. 2006, 72, 1238–1246. [Google Scholar] [CrossRef]
- Zhu, H.; Chen, M.; Wen, Q.; Li, Y. Isolation and characterization of the carotenoid biosynthetic genes LCYB, LCYE and CHXB from strawberry and their relation to carotenoid accumulation. Sci. Hortic. 2015, 182, 134–144. [Google Scholar] [CrossRef]
- Tian, L.; Musetti, V.; Kim, J.; Magallanes-Lundback, M.; DellaPenna, D. The Arabidopsis LUT1 locus encodes a member of the cytochrome P450 family that is required for carotenoid ε-ring hydroxylation activity. Proc. Natl. Acad. Sci. USA 2004, 101, 402–407. [Google Scholar] [CrossRef] [PubMed]
- Xiao, H.; Zhang, Y.; Wang, M. Discovery and Engineering of Cytochrome P450s for Terpenoid Biosynthesis. Trends Biotechnol. 2019, 37, 618–631. [Google Scholar] [CrossRef] [PubMed]
- Zhang, Y.; Liu, Z.; Sun, J.; Xue, C.; Mao, X. Biotechnological production of zeaxanthin by microorganisms. Trends Food Sci. Technol. 2018, 71, 225–234. [Google Scholar] [CrossRef]
- Buhaescu, I.; Izzedine, H. Mevalonate pathway: A review of clinical and therapeutical implications. Clin. Biochem. 2007, 40, 575–584. [Google Scholar] [CrossRef] [PubMed]
- Lado, J.; Zacarías, L.; Rodrigo, M.J. Regulation of Carotenoid Biosynthesis during Fruit Development. Sub-Cell. Biochem. 2016, 79, 161–198. [Google Scholar]
- Takaichi, S.; Mochimaru, M.; Uchida, H.; Murakami, A.; Hirose, E.; Maoka, T.; Tsuchiya, T.; Mimuro, M. Opposite Chilarity of α-Carotene in Unusual Cyanobacteria with Unique Chlorophylls, Acaryochloris and Prochlorococcus. Plant Cell Physiol. 2012, 53, 1881–1888. [Google Scholar] [CrossRef]
- SchÄFer, L.; Sandmann, M.; Woitsch, S.; Sandmann, G. Coordinate up-regulation of carotenoid biosynthesis as a response to light stress in Synechococcus PCC7942. Plant Cell Environ. 2006, 29, 1349–1356. [Google Scholar] [CrossRef]
- Kikukawa, H.; Okaya, T.; Maoka, T.; Miyazaki, M.; Murofushi, K.; Kato, T.; Hirono-Hara, Y.; Katsumata, M.; Miyahara, S.; Hara, K.Y. Carotenoid Nostoxanthin Production by Sphingomonas sp. SG73 Isolated from Deep Sea Sediment. Mar. Drugs 2021, 19, 274. [Google Scholar] [CrossRef]

| Category | Value |
|---|---|
| Genome size (bp) | 4,239,716 |
| tmRNA | 1 |
| tRNA | 61 |
| Protein-coding sequences (CDSs) | 3882 |
| chromosome G + C content (%) | 70% |
| plasmid | 2 |
| plasmid G + C content (%) | 63% |
| Pathway | Genes | Coded Protein/Enzyme | Catalytic Substrate | Catalytic Product |
|---|---|---|---|---|
| Glycolysis&Gluconeogenesis | pgm * | Phosphoglucomutase | α-D-glucose 1-phosphate | α-D-glucose 6-phosphate |
| glk | Glucokinase | α-D-glucose | α-D-glucose 6-phosphate | |
| galM | Aldose 1-epimerase | α-D-glucose | β-D-glucose | |
| pgi | Glucose-6-phosphate isomerase | α-D-glucose 6-phosphate; β-D-glucose 6-phosphate | β-D-fructose 6-phosphate | |
| fbp | Fructose bisphosphatase | β-D-fructose 6-phosphate | β-D-fructose 1,6-bisphosphate | |
| fbaB | Phosphoglycerate kinase | β-D-fructose 1,6-bisphosphate | Glyceraldehyde-3-phosphate; glycerone-phosphate | |
| tpiA | Phosphotriose isomerase | Glycerone-phosphate | Glyceraldehyde-3-phosphate | |
| gapA | Glyceraldehyde-3-phosphate dehydrogenase | Glyceraldehyde-3-phosphate | Glycerate-1,3-bisphosphate | |
| pgk | Phosphoglycerate kinase | Glycerate-1,3-bisphosphate | Glycerate-3-phosphate | |
| gpmA | Cofactor dependent phosphoglycerate mutase | Glycerate-3-phosphate | Glycerate-2-phosphate | |
| gpmI * | Cofactor independent phosphoglycerate mutase | Glycerate-3-phosphate | Glycerate-2-phosphate | |
| pckA * | Phosphoenolpyruvate carboxykinase | Oxaloacetate | Phosphoenol-pyruvate | |
| pckG # | Phosphoenolpyruvate carboxykinase | Oxaloacetate | Phosphoenol-pyruvate | |
| eno | Phosphopyruvate hydratase | Glycerate-2-phosphate | Phosphoenol-pyruvate | |
| pykF | Pyruvate kinase | Phosphoenol-pyruvate | Pyruvate | |
| korA | 2-oxoacid oxidoreductase | Pyruvate | Acetyl-CoA | |
| aceF | Dihydrolipoate acetyltransferase | S-Acetyl-dihydrolipoamide-E | Acetyl-CoA | |
| aceE | Pyruvate dehydrogenase | Pyruvate | S-Acetyl-dihydrolipoamide-E | |
| lpd | Dihydrolipoyl dehydrogenase | Dihydrolipoamide-E | Lipoamide-E | |
| sapD | Propionaldehyde dehydrogenase | Acetate | Acetaldehyde | |
| frmA | Ethanol dehydrogenase | Acetaldehyde | Ethanol | |
| Carbon fixation pathways in prokaryotes | acs | Acetate-CoA ligase | Acetate | Acetyl-CoA |
| ackA * | Acetate kinase | Acetate | Acetyl phosphate | |
| accA | Acetyl-CoA carboxylase | Acetyl-CoA | Malonyl-CoA | |
| yqeF | Acetyl-CoA acetyltransferase | Acetoacetyl-CoA | Acetyl-CoA | |
| acnA | Cis-aconitase | Cis-Aconitate | Citrate | |
| icd | Oxalosuccinate decarboxylase | 2-oxoglutarate | Isocitrate | |
| porB # | 2-oxoglutarate ferredoxin oxidoreductase | Succinyl-CoA | 2-oxoglutarate | |
| ppdK | Pyruvate-phosphate ligase | Pyruvate | Phosphoenol-pyruvate | |
| ppc | Phosphoenolpyruvate carboxylase | Phosphoenol-pyruvate | Oxaloacetate | |
| mdh | Malate dehydrogenase | Oxaloacetate | (S)-malate | |
| fumA | Fumarate hydratase | (S)-malate | Fumarate | |
| sdhA | Succinate dehydrogenase | Fumarate | Succinate | |
| sdhB | Succinate dehydrogenase | Fumarate | Succinate | |
| sucC | Succinate-CoA ligase | Succinate | Succinyl-CoA | |
| metF | Methylenetetrahydrofolate reductase | 5,10-Methylene-THF | 5-Methyl-tetrahydrofolate | |
| folD | Methylenetetrahydrofolate dehydrogenase | 5,10-Methenyl-THF | 5,10-Methylene-THF | |
| mce | Methylmalonyl-CoA epimerase | (S)-Methylmalonyl-CoA | (R)-Methylmalonyl-CoA | |
| scpA | Methylmalonyl-CoA mutase | (R)-Methylmalonyl-CoA | Succinyl-CoA | |
| meh # | 3-methylfumaryl-CoA hydratase | 3-Methylfumaryl-CoA | (3S)-Citramalyl-CoA | |
| fldA # | 2-methylfumaryl-CoA isomerase | 2-Methylfumaryl-CoA | 3-Methylfumaryl-CoA | |
| Terpenoid backbone biosynthesis | atoB | Acetyl-CoA C-acetyltransferase | Acetyl-CoA | Acetoacetyl-CoA |
| dxs | 1-deoxy-D-xylulose-5-phosphate synthase | Glyceraldehyde-3-phosphate; pyruvate | 1-deoxy-D-xylulose-5-phosphate | |
| dxr | 1-deoxy-D-xylulose-5-phosphate reductoisomerase | 1-deoxy-D-xylulose-5-phosphate | 2-C-methyl-D-erythritol 4-phosphate | |
| ispD | 2-C-methyl-D-erythritol 4-phosphate cytidylyltransferase | 2-C-methyl-D-erythritol 4-phosphate | 4-(cytidine 5′-diphospho)-2-C-methyl-D-erythritol | |
| ispE | 4-(cytidine 5′-diphospho)-2-C-methyl-D-erythritol kinase | 4-(cytidine 5′-diphospho)-2-C-methyl-D-erythritol | 2-Phospho-4-(cytidine 5′-diphospho)-2-C-methyl-D-erythritol | |
| ispDF | 2-C-methyl-D-erythritol 2,4-cyclodiphosphate synthase | 2-Phospho-4-(cytidine 5′-diphospho)-2-C-methyl-D-erythritol | 2-C-methyl-D-erythritol 2,4-cyclodiphosphate | |
| gcpE | (E)-4-hydroxy-3-methylbut-2-enyl-diphosphate synthase | 2-C-methyl-D-erythritol 2,4-cyclodiphosphate | 1-Hydroxy-2-methyl-2-butenyl 4-diphosphate | |
| ispG | (E)-4-hydroxy-3-methylbut-2-enyl-diphosphate synthase | 2-C-methyl-D-erythritol 2,4-cyclodiphosphate | 1-Hydroxy-2-methyl-2-butenyl 4-diphosphate | |
| ispH | 4-hydroxy-3-methylbut-2-en-1-yl diphosphate reductase | 1-Hydroxy-2-methyl-2-butenyl 4-diphosphate | Isopentenyl-PP or Dimethylallyl-PP | |
| ispA | Geranyl pyrophosphate synthase | Isopentenyl-PP or Dimethylallyl-PP | Geranyl-PP | |
| ispB | Octaprenyl-diphosphate synthase | (E,E)-Famesyl-PP | Octaprenyl-diphosphate | |
| ispU | Undecaprenyl diphosphate synthetase | (E,E)-Famesyl-PP | Ditrans, polycis-undecaprenyl diphosphate | |
| Carotenoid biosynthesis | crtB | 15-cis-phytoene synthase | Geranyl-geranyl-PP | Prephytoene-PP |
| crtE | Phytoene desaturase | 15-cis-phytoene | All-trans-neurosporene | |
| crtI | Phytoene desaturase | Phytoene | Lycopene | |
| crtQ | Phytoene desaturase | 15-cis-phytoene | All-trans-lycopene | |
| crtL | Lycopene β-cyclase | Lycopene | γ-Carotene | |
| crtR | β-carotene 3-hydroxylase | β-Carotene | Zeaxanthin |
Disclaimer/Publisher’s Note: The statements, opinions and data contained in all publications are solely those of the individual author(s) and contributor(s) and not of MDPI and/or the editor(s). MDPI and/or the editor(s) disclaim responsibility for any injury to people or property resulting from any ideas, methods, instructions or products referred to in the content. |
© 2023 by the authors. Licensee MDPI, Basel, Switzerland. This article is an open access article distributed under the terms and conditions of the Creative Commons Attribution (CC BY) license (https://creativecommons.org/licenses/by/4.0/).
Share and Cite
Liu, C.; Zhao, Z.; Xu, Q.; Zhang, H.; Liu, X.; Yin, C.; Yan, H.; Liu, Y. Comparative Genomic Analysis of Sphingomonas morindae sp. NBD5 and Sphingopyxis sp. USTB-05 for Producing Macular Pigment. Microorganisms 2023, 11, 266. https://doi.org/10.3390/microorganisms11020266
Liu C, Zhao Z, Xu Q, Zhang H, Liu X, Yin C, Yan H, Liu Y. Comparative Genomic Analysis of Sphingomonas morindae sp. NBD5 and Sphingopyxis sp. USTB-05 for Producing Macular Pigment. Microorganisms. 2023; 11(2):266. https://doi.org/10.3390/microorganisms11020266
Chicago/Turabian StyleLiu, Chao, Zhenzhen Zhao, Qianqian Xu, Haiyang Zhang, Xiaolu Liu, Chunhua Yin, Hai Yan, and Yang Liu. 2023. "Comparative Genomic Analysis of Sphingomonas morindae sp. NBD5 and Sphingopyxis sp. USTB-05 for Producing Macular Pigment" Microorganisms 11, no. 2: 266. https://doi.org/10.3390/microorganisms11020266
APA StyleLiu, C., Zhao, Z., Xu, Q., Zhang, H., Liu, X., Yin, C., Yan, H., & Liu, Y. (2023). Comparative Genomic Analysis of Sphingomonas morindae sp. NBD5 and Sphingopyxis sp. USTB-05 for Producing Macular Pigment. Microorganisms, 11(2), 266. https://doi.org/10.3390/microorganisms11020266

